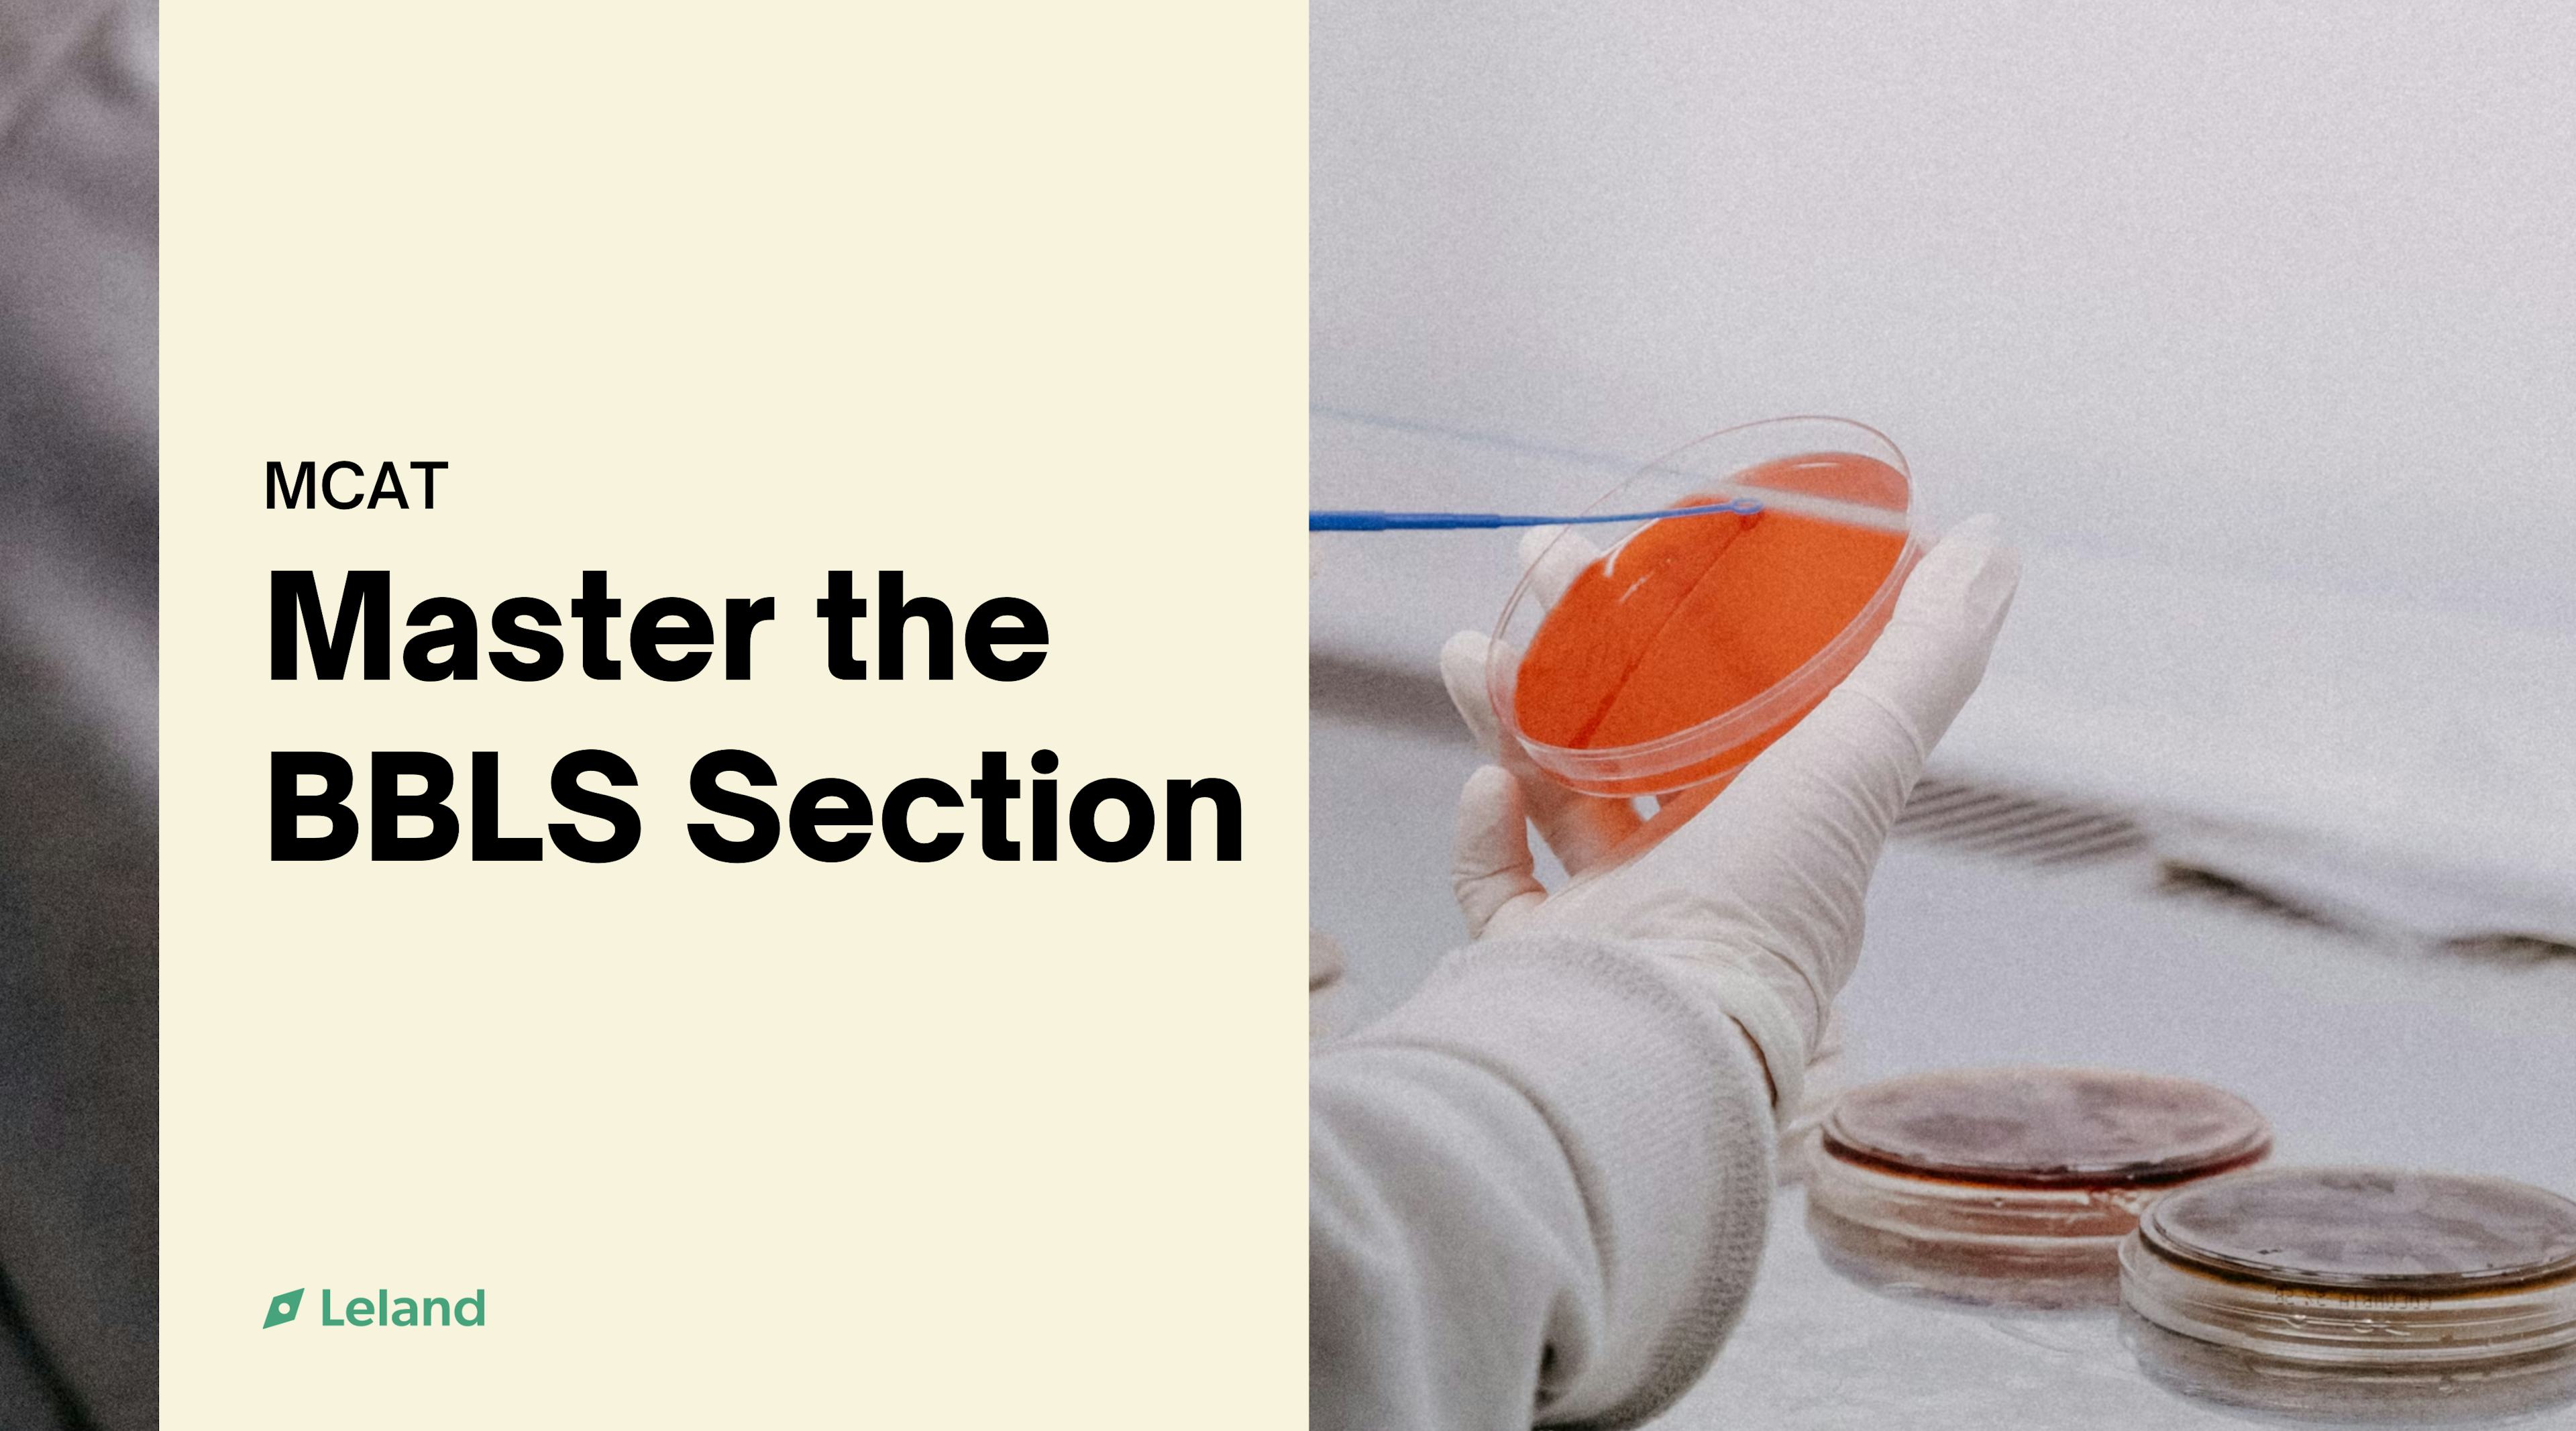

Elijah D.
5.0
(18)
1,155 min coaching
Columbia Med Student | Gates-Cambridge Scholar | MCAT Expert in CPBS

Supercoach

Studied at Columbia Vagelos College of Physicians and Surgeons
Worked at American Cancer Society
Available Monday at 3:00 PM UTC
Usually responds within 1 hour
Questions? Start chatting with this coach before you get started.
Elijah's Coaching Offerings

Nail the CPBS Section
Score in the top percentile on the CPBS section of the MCAT
Starting at $62110h+ of coaching

Crush the PSBB Section
Score in the top percentile on the PSBB section of the MCAT
Starting at $62110h+ of coaching
Master the BBLS Section
Score in the top percentile on the BBLS section of the MCAT
Starting at $62110h+ of coaching
Custom hourly · $69/hr
Get help with Biological and Biochemical Foundations of Living Systems, and Biological Foundations of Behavior, and .
Elijah also coaches for Medical School, Master’s Programs, and College. View all.
Elijah’s MCAT Qualifications
Coaches professionally
Every individual requires a specific approach to ace the MCAT—I am here to help you find yours. As a Gates-Cambridge Scholar and an incoming MD candidate at Columbia University, I bring a strong academic background and a passion for helping others succeed. My specialties lie within the Chemical and Physical Foundations of Biological Systems (scoring in the 99th percentile), the Psychological, Social, and Biological Foundations of Behavior (scoring in the 93rd percentile), and the Biological and Biochemical Foundations of Living Systems (scoring in the 90th percentile). I am committed to helping you excel in your MCAT preparation and achieve your medical school dreams. Whether you require help with developing an effective MCAT schedule, learning test-taking strategies, connection to personalized resources, or anything else, I am here to personally help you navigate your path to achieving your dream MCAT score. I am excited to work with you!
Elijah can help with:
Biological and Biochemical Foundations of Living Systems
and Biological Foundations of Behavior
Social
Psychological
Test Prep Strategy
Chemical and Physical Foundations of Biological Systems
Tailored Study Plan
Elijah also coaches for Medical School, Master’s Programs, and College. View all.
About Elijah
Growing up in the suburbs of Chicago, I witnessed the health discrepancies of my family living in urban Illinois and rural Wisconsin. Combined with my maternal lineage and my experience with a genetic cancer syndrome, I was inspired to improve health equity across populations. This led to my undergraduate studies, where I learned the importance of finding consilience between diverse fields of study, including psychology, music, and medicine. I applied these philosophies in spearheading community education and public health interventions and conducting research in both the basic sciences and psychology to begin my journey in improving health equity. Through these and other experiences, I have gained expertise leading and teaching in local and national organizations, learning the skills and strategies to achieve success in admissions into medical school, graduate programs, and competitive international fellowships. In my free time, I enjoy music composition, 3D printing and design, team sports, and running.
Why do I coach?
Navigating admission into medical school, graduate programs, and international fellowships can be convoluted and daunting. I have had to go through these processes first-hand, and mentorship from knowledgeable and supportive individuals was essential for my success and confidence. Unfortunately, finding a quality mentor who is both knowledgeable and supportive can be difficult. This is why I am drawn to coaching. Achieving success in the admissions process for these programs is completely attainable, and I am driven to use the knowledge and expertise I gained from my personal and professional experiences to help others reach their goals and dreams.
Work Experience
Chief Executive Officer
My Book Wish
November 2018 - May 2025
Oversaw the national operations of a national 501(c)(3) organization and all of its chapters as well as direct and implement the vision dictated by the National Board. Created and took direct leadership of the Missouri Chapter of My Book Wish 501(c)(3) in 2021. Initiated program in St. Louis spearheading fundraisers, donations, and community reading programs.
Basic Life Support Instructor
American Heart Association
2022 - 2025
Served as an instructor teaching and certifying hundreds of individuals in Basic Life Support. I additionally managed the training and oversight of over 15 instructors.

Research Assistant
Washington University in St. Louis
January 2023 - December 2024
Research assistant in the Dave Chen Lab investigating the development of an in vitro organoid model for the study of cutaneous squamous cell cancer and conditions contributing to lysine demethylase 6A (KDM6A) protein mislocalization in cutaneous squamous cell carcinoma (cSCC) pathogenesis.
Research Intern
American Cancer Society
May 2023 - August 2024
Selected for the 2023 and 2024 cohort of the selective ACS Diversity in Cancer Research Program at the Siteman Cancer Center. Conducted research in the Dave Chen Lab investigating conditions contributing to lysine demethylase 6A (KDM6A) protein mislocalization in cutaneous squamous cell carcinoma (cSCC) pathogenesis.
Education

Columbia Vagelos College of Physicians and Surgeons
MD
2025 - 2030
MD Candidate for Class of 2030
University of Cambridge
MPhil Population Health Sciences
2025 - 2026
Gates-Cambridge Scholar 2025

Washington University in St. Louis
Bachelor's degree, Psychological and Brain Sciences
2021 - 2025
Rodriguez Scholar, Rhodes Scholarship Finalist, Phi Beta Kappa Honorary Society Member, Commencement Speaker
Elijah was also personally admitted to
University of Chicago Pritzker School of Medicine
Washington University School of Medicine
Icahn School of Medicine at Mount Sinai
Northwestern University School of Medicine
Albert Einstein College of Medicine
Tufts University School of Medicine
Yale University
Brown University
University of Leeds
University of Wisconsin - Madison
18 Reviews
Overall Rating